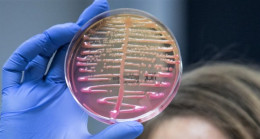

Türkiye, 6 Şubat’ta Kahramanmaraş’ın Pazarcık ve Elbistan ilçelerinin merkez üssü olduğu 7,7 ve 7,6’lık depremler sebebiyle büyük bir yıkım yaşadı. Depremin ardından devlet etkilenen 10 şehirde de tüm ekipleri ve imkanlarıyla seferber oldu. Mehmetçik ise, güvenlik, arama kurtarma faaliyetlerinin yanı sıra depremzedelerin yaralarını sarmak için de büyük bir mücadele verdi. Necip Fazıl Şehir Hastanesi önünde kurulan ve 19 konteynır, 21 çadırdan oluşan Milli Savunma Bakanlığı (MSB) Sahra Hastanesi, alanında uzman askeri hekimler, yardımcı sağlık personeli, idari ve teknik personel olmak üzere toplam 70 personelle depremin ilk günlerinden bu yana vatandaşlara sağlık hizmeti veriyor.
SAHRA HASTANESİ İÇİN REKOR KURULUM
Depremin üzerinden 24 saat geçmeden Kahramanmaraş’a ulaşan Mehmetçik, normal şartlarda kurulumu 48 ile 72 saat arasında süren Sahra Hastanesini 9 saatte rekor denilebilecek bir zaman diliminde hazır etti ve hasta kabulüne başladı. Sahra Hastanesinin açılması sonrasında bölgedeki diğer hastanelerin yükü de büyük ölçüde hafifletilmiş oldu.
TAM TEŞEKKÜLLÜ HASTANE GİBİ HİZMET VERİYOR
Her türlü acil tıbbi müdahalenin yapılabildiği, iki acil, birer radyoloji, laboratuvar, sterilizasyon ünitesi, ameliyathane, hasta koğuşu ve eczaneden oluşan Sahra Hastanesinde, bu ünitelerin çalışmasını sağlayan destek üniteleri de yer alıyor. Hastane içerisinde tıbbi tanıya yönelik her türlü laboratuvar tetkikleri, seyyar röntgen cihazı ve ultrasonografi cihazı da bulunuyor.
KAHRAMANMARAŞ’TA SAHRA HASTANESİNDE 100’E YAKIN AMELİYAT YAPILDI
Deprem bölgesinden gelen hasta ve yaralılara acil sağlık hizmeti desteği verilmesi ve depremzedelerin durumlarının stabil hale getirilmesi için görevini sürdüren hastanede 7 gün 24 saat sağlık hizmeti sunuluyor. Bugüne kadar 2 binin üzerinde müracaat alan Sahra Hastanesinde, yaklaşık olarak 100 ameliyat gerçekleştirildi.
ALINTI KAYNAK: https://www.sabah.com.tr/saglik/2023/03/01/kahramanmaras-sahra-hastanesinde-100e-yakin-ameliyat-yapildi